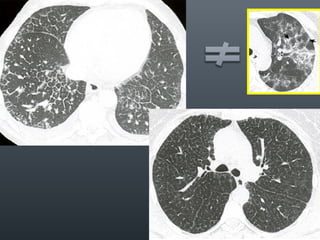
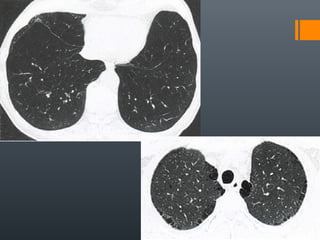

Incorporar apresentação
Baixado 73 vezes










































O documento discute vários conceitos radiológicos incluindo consolidação, atelectasia, nódulos, pseudocavidades e padrões intersticiais, fornecendo definições, sinais e diagnósticos diferenciais para cada tópico. Ele também discute a redução da atenuação pulmonar e fornece um link para mais informações.